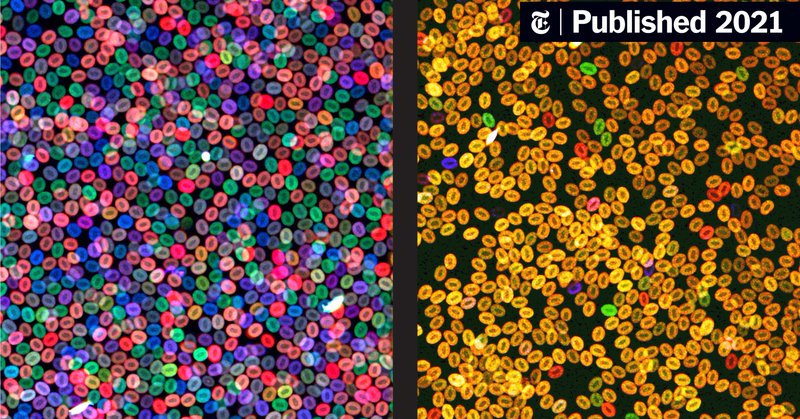
Tweet card summary image

Owen Tamplin
@ojtamplin
Followers
348
Following
17
Media
2
Statuses
31
Assistant Professor at UW-Madison studying the blood stem cell niche @UWMadison @UWCarbone @UWSCRMC
Madison, WI
Joined June 2013
Our Stem Cell Reports cover story titled, “GABA produced by multiple bone marrow cell types regulates hematopoietic stem and progenitor cells” is out today!
0
1
4
Check out our new paper! GABA produced by multiple bone marrow cell types regulates hematopoietic stem and progenitor cells: Stem Cell Reports
cell.com
Tamplin and colleagues functionally test production of GABA metabolite in the bone marrow microenvironment as a regulator of hematopoietic stem and progenitor cells. Conditional deletion of GAD...
0
0
6
Curious to check if your NIH study section has met? Check the Center for Scientific Review website!
0
0
0
Check out our new review on Frontiers in Hematology!
frontiersin.org
Hematopoietic stem cells (HSCs) undergo a functional decline during aging. The intrinsic characteristics of aged HSCs have been well-described and include a ...
0
0
4
Latest news: will be moving back to WI at end of this year after 30+ years away from home. Transitioning our program to @Morgridge_Inst and @UWMadisonCRB. Excited for our lab members to visit & plan things out. Madison has phenomenal regeneration and zebrafish communities &...
We are excited to announce that Dr. Ken Poss is joining our department! Welcome @Ken_Poss_Lab to @UWMadison, CRB and @Morgridge_Inst! https://t.co/XYKtJ0RYAT
32
19
169
Congratulations to Nicole Woodhead on winning a 2023 @UWSCRMC Research Training Award! https://t.co/5ALoiWpWLK
stemcells.wisc.edu
The SCRMC Research Training Awards were established in 2008 to recognize and provide support for promising graduate students and postdoctoral fellows of all citizenships conducting stem cell and...
0
2
4
eLife ends accept/reject decisions following peer review https://t.co/u2hejeqOIu
0
0
1
Thank you #UWMadison for promoting our work! See-through zebrafish, new imaging method put blood stem cells in high-resolution spotlight https://t.co/NGBrqnUeaw via @uwmadison
news.wisc.edu
This new technique will aid researchers as they develop therapies for blood diseases and cancers.
1
3
21
Our preprint is now published at eLife! Defining the ultrastructure of the hematopoietic stem cell niche by correlative light and electron microscopy
elifesciences.org
Multiple imaging modalities resolved the ultrastructure of single hematopoietic stem cells in their endogenous niche, allowing identification of dopamine beta-hydroxylase positive cells as a functi...
3
15
97
Congratulations to Dr. Elujoba-Bridenstine on her successful thesis defense today!!!
0
0
7
Resilient anatomy and local microplasticity of naïve and stress hematopoiesis https://t.co/mTWnBYGrLL
#bioRxiv
0
1
0
Congress Strengthens NIH’s Ability To Address Harassment in NIH-funded Activities
0
0
1
Happy #FluorescenceFriday! This is a time-lapse movie of a zebrafish embryo showing hematopoietic stem cells undergoing endothelial-to-hematopoietic transition. Extracted from a recent @Dev_journal publication by Rebecca Schiavo and @ojtamplin
https://t.co/D87aRRFAPl
1
14
34
Check out our new paper in Development! Vascular endothelial growth factor-c regulates hematopoietic stem cell fate in the dorsal aorta | Development | The Company of Biologists
0
10
56
We are looking for a highly motivated research intern to join the Tamplin lab at UW-Madison! Spread the word!
0
4
11
Take a look at our new paper on bioRxiv! Defining the ultrastructure of the hematopoietic stem cell niche by correlative light and electron microscopy
biorxiv.org
The blood system is supported by hematopoietic stem and progenitor cells (HSPCs) found in a specialized microenvironment called the niche. Many different niche cell types support HSPCs, however how...
5
12
71
Check out our new paper online in Blood! "The neurotransmitter receptor Gabbr1 regulates proliferation and function of hematopoietic stem and progenitor cells"
7
7
64